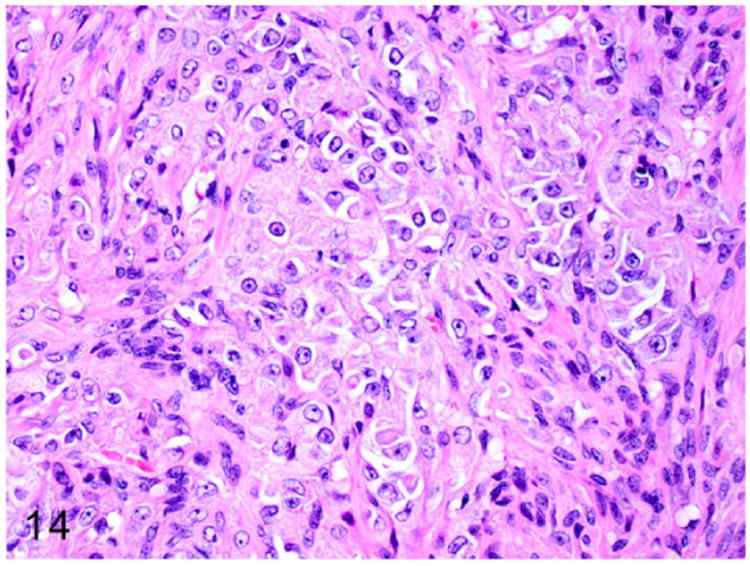
Figure 14

Abstract
Ferrets have become more popular as household pets and as animal models in biomedical research in the past 2 decades. The average life span of ferrets is about 5-11 years with onset of geriatric diseases between 3-4 years including endocrinopathies, neoplasia, gastrointestinal diseases, cardiomyopathy, splenomegaly, renal diseases, dental diseases, and cataract. Endocrinopathies are the most common noninfectious disease affecting middle-aged and older ferrets. Spontaneous neoplasms affecting the endocrine system of ferrets appear to be increasing in prevalence with a preponderance toward proliferative lesions in the adrenal cortex and pancreatic islet cells. Diet, gonadectomy, and genetics may predispose ferrets to an increased incidence of these endocrinopathies. These functional proliferative lesions cause hypersecretion of hormones that alter the physiology and metabolism of the affected ferrets resulting in a wide range of clinical manifestations. However, there is an apparent dearth of information available in the literature about the causal relationship between aging and neoplasia in ferrets. This review provides a comprehensive overview of the anatomy and physiology of endocrine organs, disease incidence, age at diagnosis, clinical signs, pathology, and molecular markers available for diagnosis of various endocrine disorders in ferrets.
Keywords: adrenal-associated endocrinopathy, adrenocortical neoplasm, aging, cysts, diabetes mellitus, endocrinopathies, endocrine tumors, estrogen-induced anemia, ferret, gonadectomy, insulinoma, islet cell tumor, multiple endocrine neoplasia, neuroblastoma, ovary, pancreatic polypeptidoma, parathyroid, pheochromocytoma, pituitary, review, teratoma, testis, thyroid
The domestic ferret Mustela putorius furo, like the skunk, mink, weasel, stoat, otter, and badger, is a carnivorous mammal that belongs to the Mustelidae family. Ferrets were domesticated more than 2000 years ago and were primarily used for hunting rabbits and for fur production in Europe. Introduced in 1875, ferrets are considered companion animals in the United States. Approximately, 7-10 million ferrets are maintained as household pets in the United States.3,36 In 1882, ferrets were introduced in New Zealand to control the burgeoning European rabbit population are now considered feral animals and they play an important role in the transmission of tuberculosis to the native species of that country.16,92
Commercial large scale production of ferrets began in the 1930s with ferrets being used as laboratory animals. In biomedical research, ferrets are used as model organisms for vaccine testing, cardiovascular pharmacology, toxicology, virology, reproductive physiology, neuronal plasticity, and behavioral studies.10,46,48 Ferrets are an excellent animal model to study the pathogenesis of influenza virus and severe acute respiratory syndrome (SARS)–associated coronaviral infections, cystic fibrosis, peptic ulcer disease, carotenoid metabolism, emesis, and NSAID-induced gastric toxicity.5,8,86 Recently, the entire 2.41 Gb of the ferret genome with 19190 protein-coding sequences has been determined.86 With the availability of genomic sequence data, ferrets can now serve as robust animal models to further study diseases like influenza, SARS, and cystic fibrosis.
Endocrine disorders are the most common disease reported in ferrets.75,76,107 Historically, ferrets have been considered to be resistant to the development of neoplasms.61,63 However, in the last 3 decades, an increased incidence of neoplasms has been reported in ferrets. The incidences of endocrine tumors are much higher in ferrets compared to other domestic animals.75,107 According to 2 different studies, approximately 40% and 53% of the tumors reported in ferrets are endocrine in origin.3,39
In retrospective studies of ferrets with tumors, simultaneous multiple tumors were found in 12-20% of affected animals.4,75,76 Although the pathogenesis of multiple tumors in ferrets has not been elucidated, ferrets are considered to be an attractive animal model to study human multiple endocrine neoplasia (MEN) syndromes. Several retrospective studies have identified pancreatic islet cell and adrenocortical tumors as the most common neoplasms in ferrets.3,63,76 The intake of carbohydrate-rich diet has been implicated in pathogenesis of insulinoma.19 The practice of gonadectomy has been associated with adrenal associated endocrinopathy, which includes adrenocortical hyperplasia and adrenocortical neoplasms.77,100,109,110
In domestic animals, the frequency of neoplasms significantly increases with the age of the animals.24 The disruption of genetic integrity and alteration of the cellular environment by the aging process facilitates carcinogenesis.71 The average life span of ferrets ranges between 5-11 years.35 The mean age of most of the endocrine neoplasms diagnosed in ferrets is between 3-5 years (Table 1).41,63,76 Several geriatric disorders such as neoplasia, gastrointestinal disorders, dental disease, cardiomyopathy, renal diseases, and cataract have been reported in aging ferrets.52 However, the information on the intricate relationship between aging and geriatric diseases in ferrets is sparse in the past and recent literature. Hence, this review provides a detailed account of various disorders affecting endocrine systems including gonads and mammary glands in ferrets and also explores available information on the incidence of endocrinopathies and its relation to aging in ferrets.
Table 1.
Endocrine Tumor Incidence by Age in Ferrets.
| Tumor Type | Age of Onset (Years) | Reference |
|---|---|---|
| Insulinoma | 4-5 | 3 |
| Adrenocortical neoplasms | 4-6 | 63, 77, 109, 113, 117 |
| Pheochromocytoma | 3.5 | 39 |
| Pancreatic polypeptidoma | 4 | 75 |
| Ovarian sex-cord stromal tumors | 2.5-5 | 20, 22, 29, 84 |
| Mammary gland tumor (black-footed ferrets) | 3 | 58 |
| Sertoli cell tumor | 5 | 7 |
| Interstitial cell tumor | 5 | 7 |
| Thyroid adenocarcinoma | 2-5 | 123 |
| C-cell carcinoma | 3.5 | 39 |
| Pituitary adenoma | 5 | 106 |
Adrenal Gland
The adrenal glands are partially surrounded by adipose tissue and peritoneum and are situated close to the craniomedial borders of the kidneys. The left adrenal gland is oval, measures 6-8 mm, and weighs 50-80 mg. The right adrenal gland is more elongate, measures 8-11 mm, and weighs 60-80 mg. The renal arteries and the aorta are the major blood vessels supplying blood to the adrenal glands. Depending on the stage of estrus cycle, the weight of the adrenal glands varies significantly in female ferrets.33,51
Histologically, a normal ferret adrenal gland is composed of a thick connective tissue capsule enclosing the parenchyma, which is composed of an outer cortex and inner medulla (Fig. 1). Like many other mammals, the adrenal cortex of the ferret has 3 main zones namely the zona glomerulosa, zona fasciculata, and zona reticularis (Fig. 1). In addition, the adrenal glands of ferrets also have zona intermedia (between zona glomerulosa and zona fasciculata) and zona juxtamedullaris (medulla).51 The zona glomerulosa forms the outer most zone of the adrenal cortex and primarily secretes mineralocorticoids such as aldosterone. The zona fasciculata forms the intermediate zone and secretes glucocorticoids such as cortisol. The zona reticularis primarily secretes androgens such as estradiol, 17-hydroxyprogesterone (17α-HPG), androstenedione, and dehydroepiandrosterone sulfate (DHEAS) in very limited amounts under normal physiological conditions.98
Figure 1.

Proliferative lesions of the adrenal gland, ferret. Normal adrenal gland. The adrenal gland has a dense fibrous capsule (arrow). The adrenal cortex (C) is divided into three zones: zona glomerulosa (g), zona fasciculata (f), and zona reticularis (r). HE, hematoxylin and eosin; M, medulla. Hematoxylin and eosin (HE).
Adrenal-associated Endocrinopathy
Adrenal-associated endocrinopathy (AAE) is a common disease observed in pet ferrets residing in the United States,28,100,113,117,119 Europe,14,30,109 and Japan.77 Hyperadrenocorticism (HAC) associated with adrenal gland tumors in ferrets was first reported in the United States in 1987.40 The prevalence of HAC among ferrets has increased from 30% to 70% in the last 2 decades.110 The increase in prevalence of AAE in the United States may be attributed to inbreeding, altered photoperiods, and gonadectomy at an early age (4-6 weeks). AAE has been diagnosed most frequently in ferrets between 3-4 years of age without an apparent sex predilection.100,109,113,117
In ferrets, AAE is commonly associated with elevated levels of sex steroids rather than cortisols. The cortisol levels are typically within the normal limits and are rarely elevated in ferrets affected with AAE.40,98,103 Hence AAE is most often a distinctly different condition from HAC reported in dogs and humans. Furthermore, the contralateral adrenal gland can remain unaffected in ferrets with AAE.57 The serum concentration levels of sex steroids such as estradiol, 17α-HPG, androstenedione, and DHEAS are commonly elevated in ferrets affected with AAE.98 Chronic hyperestrogenism as noted in AAE usually leads to vulvar enlargement in females and squamous metaplasia of prostate in male ferrets.75
The pathogenesis of AAE in ferrets is pituitary-independent given the normal plasma concentration of both adrenocorticotropic hormone and α-melanocyte-stimulating hormone.104 However, the pathogenesis of AAE involves disruption of the negative feedback mechanism of gonadotropin-releasing hormone (GnRH) and luteinizing hormone (LH) release from the hypothalamus. The steroid producing cells of the adrenal cortex and gonads are derived from the common progenitor cells of the urogenital ridge during embryogenesis. In neutered ferrets, lack of sex steroids from the gonads leads to a loss of GnRH down-regulation in the hypothalamus that result in increased LH release from the pituitary. Chronic stimulation of steroid producing cells of the adrenal cortex by LH results in increased sex steroid synthesis.105 It has been postulated that the LH receptors of steroid producing cells in AAE-affected ferrets may have altered functional status. This alteration in the LH receptor results in increased production of androstenedione and 17α-HPG in response to GnRH stimulation.105 The role of gonadectomy in pathogenesis of AAE is further supported by studies in mice.12
In ferrets, AAE-associated clinical manifestations are primarily due to elevated sex hormones. The most common clinical sign of AAE in ferrets is progressive, symmetrical alopecia with or without pruritis. The alopecia extends from the tail to the flanks, dorsum, and abdomen (Fig. 2). Pruritis, if reported is most frequently observed on the dorsum adjacent to the shoulder region. Pruritis and alopecia are often associated with easy epilation, erythema, and excoriation.97 The alopecia is cyclical with seasonal recurrence and results in permanent loss of hair. The AAE affected female ferrets have an enlarged vulva with mucoid discharge and mammary hyperplasia. Male ferrets affected by AAE may present with dysuria, stranguria, or anuria due to partial or complete urinary obstruction, and enlarged cystic prostate glands.21,62,99
Figure 2.

Proliferative lesions of the adrenal gland, ferret. Adrenal-associated endocrinopathy. Bilaterally symmetrical dorsolateral truncal alopecia. The causative adrenocortical tumor is shown in Fig. 3.
AAE is most commonly associated with proliferative lesions such as adrenocortical hyperplasia, adrenocortical adenoma, and adrenocortical carcinoma, with reported prevalence of 56%, 16%, and 26%, respectively.117 On gross examination, the adrenal glands affected by these proliferative lesions were cystic and discolored with irregular enlargement.6
Dermal lesions associated with AAE are consistent with endocrine alopecia and include global telogenization, atrophy of hair follicles and adnexal glands, follicular keratosis, epidermal thinning, orthokeratotic hyperkeratosis, and evidence of self-induced trauma in the areas of pruritis.64,75,83
Multiple cystic structures adjacent to the urinary bladder were reported in the urogenital tracts of both male and female ferrets afflicted by AAE.21,62 The variably sized fluid-filled cysts were lined by transitional epithelium or squamous epithelium with or without keratinization. The epithelial lining was surrounded by a muscular layer and an outer serosal layer.62 The cystic urogenital structures in female ferrets were speculated to be either due to congenital abnormality such as mesonephric or paramesonephric duct cysts, urachal cysts, and bladder diverticula or stimulation of pluripotent sinus cells of urethral epithelium by elevated sex hormones.62
The prostatic cysts in male ferrets were lined by keratinized squamous epithelium. The cysts contain abundant lamellated keratin and abundant neutrophils. In AAE-affected male ferrets, chronic stimulation by estrogen led to squamous metaplasia of prostatic glandular epithelium and cyst formation similar to lesions observed in other species.21 Bone marrow suppression, pancytopenia, and nonregenerative anemia due to estrogen toxicity are rare in AAE-affected ferrets.97,101
AAE is diagnosed based on incidence and characteristic clinical presentation. Confirmatory diagnosis is made based on a serum hormone assay panel that consists of estradiol, androstenedione, and 17α-HPG. The normal range for sex hormone levels in intact and neutered ferrets are provided in Table 2.35
Table 2.
Normal Sex Hormone Levels in the Serum of Ferrets.
| Sex Hormone | Intact Ferrets | Neutered Ferrets | |
|---|---|---|---|
|
|
|
||
| Male | Female | Either Sex | |
| Estradiol (pmol/L) | 103-238 | 109-299 | 30-180 |
| 17α-hydroxyprogesterone (nmol/L) | <0.1-1.9 | <0.1-20.4 | <0.1-0.8 |
| Androstenedione (nmol/L) | <0.1-10.8 | <0.1-30.6 | <0.1-1.5 |
In 1 study, urinary cortisol to creatinine ratio (UCCR) was significantly increased in ferrets affected by AAE.44 In a subsequent report, the increase in cortisol levels was not involved in the pathogenesis of AAE, which limited the UCCR usefulness in the diagnosis of AAE in ferrets.98 Also, changes in shape, structure, echogenicity, and increased thickness of the adrenal glands have been used as criteria to diagnose HAC by ultrasonography.57 Ultrasonography can be used only as an adjunct diagnostic tool due to low sensitivity of detecting AAE in the early stages of the disease.57 The cornification of preputial epithelium has also been reported to be a reliable indicator of AAE in castrated male ferrets.94
Proliferative Lesions of Adrenal Cortex
The adrenocortical tumors are the second most common neoplasm in ferrets.4,41,76,77 In ferrets, removal of gonads leads to disruption of the negative feedback mechanism of GnRH and subsequent LH release. A fraction of steroid producing cells of the zona fasciculata and reticularis elaborate sex steroids rather than cortisol due to chronic stimulation by persistently elevated LH levels.12,13,105,109,110 The phenomenon of gonadectomy-induced adrenocortical tumor formation has been reported in other species such as mice, rats, hamsters, and guinea pigs.12,13
The proliferative lesions in the adrenal cortex of ferrets manifests as hyperplasia, adenoma, and carcinoma. On gross examination, these proliferative lesions reveal nodular or diffuse adrenal gland enlargement, discoloration, cyst formation (Fig. 3), and poor demarcation of the corticomedullary junction. The histological features of adrenocortical hyperplasia and adrenocortical neoplasms are described in Table 3.41
Figure 3.

Proliferative lesions of the adrenal gland, ferret. Adrenocortical tumor. Cystic right adrenal gland (black arrow) and an enlarged neoplastic left adrenal gland (white arrow) embedded within adipose tissue.
Table 3.
Histopathologic Features of Proliferative Adrenocortical Lesions.
| Hismiddleathologic Feature | Adrenocortical Hyperplasia | Adrenocortical Adenoma | Adrenocortical Carcinoma |
|---|---|---|---|
| Nodularity | Multiple, variably sized, and discrete | Single, expansile, and >1 cm in diameter | Exceedingly large |
| Adrenomegaly | May be present | Present | Present, even palpable by external examination |
| Demarcation | Well-demarcated | Poorly demarcated | |
| Cellular features | Well demarcated cells | Well-differentiated cells to polygonal cells with large nuclei and prominent nucleoli | |
| Mitotic rate | Rare | <1 per 10 high-power field | >1 per 10 high-power field |
| Necrosis | Infrequent | Frequent and extensive | |
| Metastasis | Absent | No invasion or metastasis | Vascular invasion and distant metastasis |
Adrenocortical Hyperplasia
Adrenomegaly is not a prominent feature of adrenocortical hyperplasia.41 Histologically, the presence of multiple nodules is suggestive of nodular cortical hyperplasia. The hyperplastic nodules are well demarcated from the adjacent normal parenchyma. The adrenocortical cells within the hyperplastic nodules are well-differentiated and often contain numerous cytoplasmic vacuoles (Fig. 4). Mitotic figures are rarely seen in adrenocortical hyperplasia.41
Figure 4.

Proliferative lesions of the adrenal gland, ferret. Focal adrenocortical hyperplasia. The mass is formed by large clear cells with vacuolated cytoplasm. HE.
Solitary or multiple cysts and tubular structures are occasionally encountered as an incidental finding in normal, hyper-plastic, and neoplastic adrenal glands of ferrets.41,79 These cystic structures often affect the right adrenal gland (Fig. 3) due its close proximity to the caudate liver lobe.79 On gross examination the cysts contain waxy translucent material. Histologically, the cysts are lined by single layer of attenuated low cuboidal epithelium. The cysts contain homogenous eosinophilic material (Fig. 5) occasionally admixed with cellular debris and mineral. The epithelial cells lining the cysts demonstrate strong immunoreactivity to cytokeratin 7, 14, 19, and AE1/AE2, which suggests that the cysts are biliary in origin.79
Figure 5.

Proliferative lesions of the adrenal gland, ferret. Cysts of probable biliary origin, adrenal gland (from Fig. 3). The right adrenal gland and adjacent adipose tissue are disrupted by multiple variably sized cysts lined by attenuated low cuboidal epithelium and containing homogenous eosinophilic proteinaceous material. HE.
Adrenocortical Adenoma
Adrenocortical adenomas are expansile, solitary lesions of adrenal cortex that often exceed 1 cm in diameter and result in adrenomegaly (Fig. 3).41 Histologically, adenomas are well demarcated and often compress the surrounding normal tissue (Fig. 6). The adenomas are composed of well-differentiated adrenocortical cells with intracytoplasmic vacuolations and polygonal cells with a large nucleus and prominent nucleolus (Fig. 6). Cellular atypia is characterized by mild anisocytosis and anisokaryosis. Mitotic figures average less than 1 per 10 high-power fields (HPFs).
Figure 6.

Proliferative lesions of the adrenal gland, ferret. Adrenocortical adenoma (from Fig. 3). Neoplastic adrenocortical cells compress adjacent normal adrenocortical tissue (top right).
A single case of aldosterone-secreting adrenocortical adenoma was reported in a 6-year-old female ferret with a history of alopecia, pruritus, lethargy, and chronic cough.28 Clinical chemistry findings were suggestive of Conn's syndrome and AAE with hyperaldosteronemia, hypokalemia, respiratory acidosis, hypertension, azotemia, elevated sex hormones (such as estradiol, 17a-HPG, and androstenedione), and nonregenerative anemia.28 Gross examination revealed a friable mass within the left adrenal gland. Histologically, the adrenocortical adenoma was characterized by unencapsulated moderately cellular dense sheets of round cells with a necrohemorrhagic core. Neoplastic cells had basophilic vacuolated cytoplasm and round nuclei with 1-2 nucleoli. The neoplastic cells formed acinar structures and were supported by fine fibrovascular stroma. Cellular atypia was characterized by mild anisocytosis and anisokaryosis. Mitotic figures were rare. The neoplastic cells demonstrated positive immunoreactivity to aldosterone.28
Adrenocortical Spindle Cell Neoplasm
Proliferation of the spindle-cell component in both hyperplastic and neoplastic lesions of the adrenal cortex has been reported in ferrets.43,63,81 Ferrets affected with this tumor subtype were 2-8 years old, with a median age of 4 years. Both intact and neutered ferrets were affected. The median ages of affected male and female ferrets were 4 and 3 years, respectively.81 Adrenocortical carcinomas and adenomas with proliferative spindle cell component were classified as mixed carcinomas and adenomas. Histologically, the spindle cells within the adrenal cortex extended from the stroma and variably replaced the adrenocortical cell packets. The spindle cells resembled smooth muscle cells with a small amount of cytoplasm and elongated nuclei. Ultrastructurally, the spindle cells contained thin contractile filaments. These spindle cells were positive for smooth muscle actin and desmin, stain variably for vimentin, and were negative for cytokeratin and S-100 protein.43 A recent study demonstrated positive immunoreactivity for estrogen receptors in mixed adenocarcinomas and adenomas. The spindle cell component with estrogen receptor immunoreactivity correlated with high malignancy, a decreased disease-free interval, and decreased survival time.81
Adrenocortical Carcinoma
Adrenocortical carcinomas are large neoplasms (Fig. 3) with histological features closely resembling that of adenomas.41 In the carcinomas, the well-differentiated adrenocortical cells with intracytoplasmic vacuoles and angular proliferating cells are supported by fibrous connective tissue stroma (Fig. 7). Cellular atypia such as large nuclei, prominent nucleoli, anisocytosis, and anisokaryosis are not considered to be features of malignancy.4,41 However, mitotic figures greater than 1 per 10 HPF, metastasis to different organs, invasion of blood vessels, and necrotic foci are generally considered as features of malignancy in adrenocortical carcinoma.41
Figure 7.

Proliferative lesions of the adrenal gland, ferret. Adrenocortical carcinoma. The neoplasm is composed of clear cells with pale vacuolated cytoplasm and polygonal cells supported by fibrous connective tissue stroma. Hematoxylin and eosin (HE).
Adrenocortical carcinoma with myxoid differentiation is an infrequent histologic variant of adrenocortical carcinoma reported in 15 male and female ferrets.88 The ferrets were 3-9 years of age with a mean age of 5.4 years, and were neutered by 6 months of age. The myxoid variant of adrenocortical carcinoma was characterized by poorly differentiated small polygonal adrenocortical cells (Fig. 8). The neoplastic cells often formed lumen-like spaces (Fig. 8) filled with Alcian blue (pH 2.5)-positive acidic mucopolysaccharides. The myxoid variant of adrenocortical carcinoma was reported to be highly malignant with an increased incidence of metastasis.88
Figure 8.

Proliferative lesions of the adrenal gland, ferret. Adrenocortical carcinoma with myxoid differentiation. Neoplastic cells often form cystic spaces that contain amphophilic to pale basophilic material (mucin). HE.
Immunohistochemical techniques can be used for diagnosis and to differentiate benign and malignant adrenocortical proliferative lesions. Increased expression of cytochrome b5 (Supplemental Fig. 1) and cytochrome P-450 17α-hydroxylase/C (17, 20)-lyase (CYP 17) (Supplemental Fig. 2), were demonstrated exclusively in proliferative adrenal lesions such as adrenocortical hyperplasia, adenomas, and carcinomas. The cytochrome b5 and CYP17 are considered to be regulators of cortisol and adrenocortical androgen synthesis in the adrenal gland.26,115 Furthermore, expression of cytochrome b5 and aromatase mRNAs that are involved in androgen, estrogen, and inhibin synthesis is upregulated in adrenal neoplasms.26 Malignant adrenocortical tumors with myxoid differentiation expressed vimentin, inhibin-α (Supplemental Fig. 3), and synaptophysin.88 The transcription factor GATA-4 was identified as a marker for anaplastic adrenocortical tumors in ferrets (Supplemental Fig. 4).87 Novel genetic and epigenetic markers were identified recently in mice and ferrets (Tables 4 and 5).102 The nuclear immunoreactivity of FoxL2, a transcription factor, was upregulated in ferrets with adrenal cortical nodular hyperplasia, adrenocortical adenoma, and adrenocortical carcinoma.102 The RNA expression profiling and candidate gene approach identified upregulation of genes such as Insl3, Spinlw1, and FoxL2 in adrenocortical neoplasms of gonadectomized mice.102 The above-mentioned genes were involved in sex steroid production in adrenocortical cells. Epigenetic modification of promoter region by hypomethylation led to upregulation of Igfbp6 and Foxs1 genes in adrenocortical neoplasms of gonadectomized mice.102
Table 4.
Novel Genetic and Epigenetic Markers of Adrenocortical Neoplasms in Normal and Neutered Male Mice and Ferrets.
| Gene/Protein | Normal Expression and Function | Expression in Adrenal Neoplasms |
|---|---|---|
| Serine peptidase inhibitor-like, with Kunitz and WAP domains 1 (Spinlw1) | Sertoli cells and epididymal cells | Upregulation of gene expression |
| Insulin-like 3 (Insl3) | Interstitial cells | Overexpression of protein |
| Forkhead box L2 (Foxs1) | Sertoli cells, periendothelial cells of testis, neural crest derivatives, and subcapsular adrenocortical cells | Promoter hypomethylation and gene overexpression |
Table 5.
Novel Genetic and Epigenetic Markers of Adrenocortical Neoplasm in Normal and Neutered Female Mice and Ferrets.
| Gene/Protein | Normal Expression and Function | Expression in Adrenal Neoplasms |
|---|---|---|
| Insulin-like 3 (Insl3) | Theca interna cells | Protein overexpression |
| Forkhead box L2 (FOXL2) | Interstitial and granulosa cells | Protein overexpression |
| Insulin related growth factor binding protein 6 (Igfbp6) | Somatic cells of ovary. IGFBP6 binds to IGF1 and 2 and plays vital roles in growth, function, and differentiation of adrenocortical cells | Promoter hypomethylation and gene upregulation |
Other Adrenal Neoplasms
Teratomas are rare neoplasms composed of tissues from all the 3 germ layers. Adrenal glands are considered to be the most common site of origin for teratomas in ferrets.41 Four teratomas affecting either single or both adrenal glands were recently reported. Ferrets of either sex were affected between 4 months to 3 years of age.121 Unlike proliferative lesions from the adrenal cortex and medulla, hormones are not elaborated by teratomas. Teratomas cause marked compression of adjacent normal adrenal cortex and medulla. Histologically, teratomas of the adrenal gland are composed of well-differentiated epithelial, endodermal, and mesenchymal tissues such as skin, bone, adipose tissue, pancreatic acini, glandular epithelium of respiratory and gastrointestinal tracts, brain, rudimentary teeth, and smooth muscle.41
Neuroblastoma was diagnosed in a 5-year-old castrated male ferret with a history of acute hind limb paresis, bladder atony, and a subcutaneous mass in the lumbar (L2-L4) region.78 The neoplasm extended from the left adrenal gland to the abdomen and subcutaneous tissue dorsally and involved the caudal vena cava. Histologically, the lobulated neoplastic mass was composed of small spindle to polygonal neoplastic cells arranged in cords and supported by fibrous connective tissue. The neoplastic cells had eosinophilic cytoplasm, and oval nuclei. Mitotic figures averaged 2-3 per HPF. The neoplastic cells demonstrated intense immunoreactivity to S-100 protein, neuron specific enolase, neurofilament, beta-III tubulin, doublecortin, and a lower degree of immunoreactivity to chromogranin A.78
Adrenal pheochromocytomas are rarely reported in ferrets.39,63,77,113 Pheochromocytoma of the adrenal gland along with C-cell carcinoma of thyroid gland, adrenocortical adenoma, and pancreatic islet cell carcinoma was reported in a 10-year-old castrated male ferret.39 Histologically, the pheochromocytoma was an expansile and well-demarcated mass (Fig. 9). The neoplasm was composed of polyhedral neoplastic cells arranged in sheets, nests, and packets separated by branching fibrous connective tissue stroma (Fig. 10). Neoplastic cells had variably distinct cell borders, scant to moderate granular, and pale eosinophilic cytoplasm. Nuclei were round to oval with finely stippled chromatin and indistinct nucleoli (Fig. 10). Mitotic figures were rare. The presentation of tumors in different endocrine organs in this ferret had a close resemblance to MEN syndrome reported in humans and other domestic animals.39
Figure 9.

Proliferative lesions of the adrenal gland, ferret. Pheochromocytoma and cortical adenoma, adrenal gland. A well-demarcated expansile pheochromocytoma that compresses an adjacent adrenocortical adenoma (on the left). HE.
Figure 10.

Proliferative lesions of the adrenal gland, ferret. Higher magnification of Fig. 9. Polyhedral neoplastic cells are arranged in nest and packets supported by fine fibrovascular stroma. HE.
In humans, the MEN syndromes are associated with genetic alterations in tumor suppressor genes and are inherited as autosomal dominant traits.90 The 2 major forms of MEN reported in humans are MEN1 and MEN2.59,90 The MEN1 is derived from an alteration in tumor suppressor menin (MEN1).91 The MEN2 are derived from germ-line mutations in the Rearranged during Transfection (RET) gene, a proto-oncogene that results in RET gene gain of function variant.59,90 MEN-like lesions have been reported in domestic animals.25,55,95,96,112,116 The MEN1 and RET genes from ferrets have been sequenced. The ferret MEN1 gene had 97.7% and 99.4% homology with the human and dog MEN1 genes, respectively. The ferret RET gene had 97.6% and 100% homology to human and dog RET genes, respectively.54 However, no mutations have been identified in the MEN1 and RET genes of ferrets with endocrine tumors. Further studies may provide additional information on the role of these genes in carcinogenesis of multiple endocrine tumors in ferrets.
Endocrine Pancreas
The pancreas is a V-shaped elongated organ with right and left limb joined by a body close to the pylorus. The pancreatic vasculature is composed of cranial and caudal pancreatic arteries and the pancreatic branch of the splenic artery. Lymphatics from the pancreas drain into the duodenal lymph nodes.75 The endocrine pancreas or pancreatic islets comprises 2% of the total pancreatic tissue and is composed of 4 cell types. Approximately 60-75% are β-cells that secrete insulin, 20% are α-cells that secrete glucagon, and low numbers of δ-cells that secrete somatostatin and F or P cells that secrete pancreatic polypeptide.68
Insulin-Secreting Pancreatic Islet Cell Tumor
Insulinoma or pancreatic islet β-cell tumor is the most common neoplasm in ferrets.4,63 Insulinomas are frequently reported in ferrets from the United States, Japan,4,63,76 Netherlands,67 and sporadically from the United Kingdom30,66 and Australia.60 The incidence of insulinoma in ferrets was 22% and 25% in 2 reports.3,63 Ferrets are usually diagnosed with insulinoma at a median age of 5-years with ages ranging from 2 to 7 years.3 An increased incidence of insulinomas has been reported in male ferrets.4,17
The predisposing factors for the development of islet cell tumors in ferrets are thought to include high-carbohydrate diet and MEN-like hereditary factors. While whole prey and fresh meat are the normal diet of ferrets used for hunting, the commercial diet fed to pet and laboratory ferrets is high in carbohydrates. The carbohydrate-rich diet is thought to cause hyperplasia and neoplastic transformation of the pancreatic β–cells.19,75
Histologically, lesions in the pancreatic islets are classified as hyperplasia, adenoma and adenocarcinoma. Carcinomas appear to be the predominant type of neoplasm compared to the adenomas.17,31 All these lesions can be functional, synthesizing excessive insulin and causing similar clinical signs.17 Approximately 94% of the insulinomas are functional neoplasms, and are often found as incidental necropsy findings in aging ferrets.41,118 The negative feedback regulators for insulin production such as hypoglycemia and hyperinsulinemia exert no or little control over insulinomas. Insulinomas in ferrets feature a high recurrence rate but have a low rate of metastases.3,34 Those that metastasize spread to the pancreas, liver, spleen, and lymph nodes.17,34,69,70,118 No correlation between clinical course of the disease and histologic features of insulinomas has been reported.31,118
The clinical signs of insulinoma in ferrets are generalized lethargy, weight loss, ataxia, star gazing, stupor, seizures, and hind limb ataxia. Ptyalism and pawing at the mouth are commonly observed in ferrets with insulinoma.17,31,70 Seizures are less frequently observed in ferrets due to the gradual onset of hypoglycemia, an increased tolerance to hypoglycemia, and the sedentary lifestyle of pet ferrets.17,31,70
The gross and microscopic features of the insulinomas are similar to those seen in other species.41 They are multiple, red-brown, firm nodules that measure up to 1 cm in diameter. Histologically, insulinomas are expansile, well circumscribed, and rarely infiltrative neoplasms (Fig. 11). Insulinomas are composed of nests, packets, and cords of cells that palisade around blood vessels (Fig. 12). The neoplastic cells are well-differentiated and cuboidal to columnar with eosinophilic granular cytoplasm and rare mitotic figures41 and are supported by fine fibrovascular stroma. Insulinomas are well-differentiated, hence vascular invasion and distant metastasis are primary criteria to diagnose malignancy in ferrets (Supplemental Figs. 5 and 6).
Figure 11.

Pancreatic islet cell neoplasm (insulinoma), ferret. Expansion and fusion of multiple proliferating neoplastic islets. HE.
Figure 12.

Higher magnification image of Fig. 11. Cords of well-differentiated neoplastic islet cells palisade around blood vessels. HE.
According to Whipple's triad a presumptive diagnosis is based on the following criteria: (1) hypoglycemia (≤60 mg/dL), (2) manifestation of neurologic signs, and (3) abatement of signs with glucose administration. Other causes of hypoglycemia such as hepatic disease, sepsis, starvation and HAC should be ruled out.19,75 Abdominal radiography and ultrasonography are of limited value in diagnosis of insulinoma.17 Hematology, urinalysis, and serum biochemistry (excluding hypoglycemia) are typically normal for ferrets with insulinoma.17,75 Evaluation of serum insulin and insulin/glucose ratio is not routinely used in diagnosis of insulinoma due to lack of specificity and appropriate reference intervals.19,75
Confirmatory diagnosis is made based on histologic examination. Insulin, glucagon, somatostatin, pancreatic polypeptide, and the neuroendocrine markers chromogranin A, synaptophysin, and neuron-specific enolase are used as immunohistochemical markers to characterize pancreatic islet cell tumors in ferrets.2,49,66
Pancreatic Polypeptidoma
Multiple pancreatic endocrine tumors were reported in a 4-year-old castrated male ferret.75 Clinical signs of intermittent depression, diarrhea, melena, and progressive weight loss were associated with the pancreatic endocrine tumors. Serum biochemical changes include hyperpancreatic polypeptidoma, hyperinsulinemia (nonfasting), and hypergastrinemia. On gross examination multiple 1-5 mm tan to reddish brown nodules within the pancreas and adjacent mesentery along with gastric ulcers were observed. Histopathologic evaluation of the pancreatic tumors revealed pancreatic islet cell tumor. Elevated levels of pancreatic polypeptide and normal levels of gastrin were extracted from the pancreatic endocrine neoplasms. These findings were highly suggestive of pancreatic polypeptidoma. Pancreatic polypeptidoma are the most commonly reported tumors in humans with MEN-1114 and rarely in dogs.15,23,82 These rare neoplasms arise from pancreatic islet cells that secrete the 36 amino acid pancreatic polypeptide. Pancreatic polypeptide plays vital role in basal gastric acid secretion, gastrointestinal motility, and pancreatic exocrine secretion.73
Diabetes Mellitus
Diabetes mellitus has been rarely reported in domestic ferrets and black footed ferrets. The age of the affected ferrets ranged between 2 to 7.5 years. Both male and female ferrets were affected and all the domestic ferrets were neutered.9,14,18,47,89 Transient episodes of diabetes mellitus were reported in ferrets surgically treated for insulinomas by nodulectomy or partial pancreatectomy.75,101 Like other species, the sequelae of spontaneous diabetes in ferrets is diabetic ketoacidosis, a metabolic derangement that results in decreased survival.75
Risk factors associated with diabetes in ferrets include obesity, pancreatitis, and AAE.14,89 The clinical signs in the affected ferrets are polyuria, polydipsia, polyphagia, dehydration, weight loss, lethargy, muscle twitching, hind limb paresis, and ataxia. The clinicopathological abnormalities reported in diabetic ferrets are hyperglycemia, hypercholesterolemia, and glycosuria. Changes resulting from diabetic ketoacidosis are ketonemia, hypokalemia, hyponatremia, hypochloremia, hypobicarbonemia, and ketonuria.9,18,19,47,89
Gross necropsy findings in diabetic ferrets are bilateral alopecia, abundant adipose tissue in the thoracic and abdominal cavity, tan friable liver with rounded edges, and unremarkable pancreas covered by abundant peripancreatic fat. Primary histopathological lesions in these ferrets include pancreatic islets with diffuse, marked vacuolation of β-cells and renal tubular epithelial cells that contain PAS-positive, amylase-labile material (glycogen). The epidermis is atrophied with minimal hair follicles in telogen phase.9,18,89 Secondary histologic lesions are hepatic lipidosis and arteriosclerosis.18,89 In contrast to humans, nonhuman primates, and cats, there is no evidence of amyloid polypeptide deposition in ferrets affected with diabetes mellitus.85 It is hypothesized that obesity and high carbohydrate diet lead to decreased release of insulin and/or increased peripheral resistance to insulin. The overall clinical presentation in most of these ferret cases is consistent with type-II diabetes mellitus.9,18,47,89 However, one of the affected ferrets was diagnosed with a rare form of type-I diabetes mellitus associated with HAC and chronic pancreatitis.14 Histological examination in this instance revealed a decreased number of β-cells in the pancreatic islets with focal lymphoplasmacytic pancreatitis and negative immunoreactivity to insulin. While the left adrenal gland was affected by adrenocortical carcinoma, the right adrenal gland was disrupted by nodular hyperplasia. Although pancreatitis has been associated with diabetes mellitus in other species, the role of inflammation in diabetes mellitus was not confirmed in this ferret.14 Most of the affected ferrets with atrophic dermatoses also had adrenal lesions. Hence, the skin lesions are not specific for diabetes mellitus.
Ovary
In sexually mature ferrets, the ovaries are located caudal to the kidneys, measure 0.45 cm × 0.55 cm × 0.21 cm and weigh 94-183 mg. The left and right ovarian arteries from the aorta supply the corresponding ovaries. The lymphatics from the ovaries drain into the lumbar lymph nodes. The ovaries are innervated by sympathetic axons from renal and aortic plexuses.33
Ovarian Sex-Cord Stromal Neoplasms
Spindle cell neoplasms of the ovarian stroma have been reported in ferrets.20,22,29,53,63,76,84,111 These neoplasms originated from granulosa cells, theca cells, and/or fibroblasts. Granulosa cell tumor, thecoma, luteoma, leiomyoma, fibromyoma, and fibroleiomyoma have been reported in ferrets.22,41,63,76 These spindle cell tumors have similar cellular morphology and immunohistochemistry is recommended for confirmatory diagnosis.41
Most of these tumors are clinically nonfunctional except for causing reproductive failure and can be an incidental finding during necropsy.41 In contrast, the sex-cord neoplasms of ovaries are functional tumors that secrete estrogens, androgens and other intermediate metabolites. Clinical signs in these cases often resemble AAE due to excess secretion of sex steroids such as androstenedione and 17α-HPG.84
Grossly, these steroid-producing neoplasms are yellow to orange due to the intracytoplasmic lipid vacuoles.84 Histologically, the ovarian architecture is completely effaced and replaced by the lobulated expansile mass (Fig. 13). The biphasic neoplasm is predominantly composed of spindle cells and polygonal cells that are supported by dense fibrous connective tissue (Fig. 14). The spindle shaped neoplastic cells are frequently arranged in interlacing fascicles, have indistinct cell borders, moderate amount of eosinophilic cytoplasm, and elongated nuclei. The polygonal neoplastic cells are arranged in cords forming tubule-like structures, have vacuolated cytoplasm, and round to oval nuclei with prominent nucleoli. Sex-cord stromal tumors can be characterized and differentiated from smooth muscle neoplasms based on their positive immunoreactivity to markers such as calretinin and inhibin-α.
Figure 13.

Sex-cord stromal tumor, ovary, ferret. Ovarian architecture is effaced by a lobulated highly cellular spindle cell neoplasm supported by dense fibrous connective tissue. HE.
Figure 14.
Higher magnification of Fig. 13. The biphasic neoplasm is composed of interlacing streams and bundles of spindle cells and polygonal cells arranged in cords. HE.
Other Ovarian Tumors
Granulosa cell tumors are also reported in ferrets.63,76 No clinical signs have been reported with these tumors. The tumors are often cystic and hemorrhagic on gross examination. Histologically, the neoplasm is composed of small cells arranged in sheets that form rosettes (Call-Exner bodies). A solitary case of a virilizing form of granulosa cell tumor called arrhenoblastoma has been reported in a ferret.41
Thecomas are a benign subtype of ovarian sex-cord stromal tumors previously reported in ferrets.20,63,76 Affected ovaries are firm, smooth, and lobulated with a solid homogenous yellow cut surface.20 Thecomas may be occasionally associated with cystic endometrial hyperplasia.20
Estrogen-Induced Anemia
Female ferrets are susceptible to a variety of endocrine disorders that affect the genitourinary tracts.38 Female ferrets are induced ovulators and if not bred they remain in estrus for the remainder of the breeding season.37 The increased level of circulating estrogen due to prolonged estrus results in bone marrow depression.11,56
Clinical signs due to prolonged estrus are anorexia, depression, lethargy, weight loss, bilaterally symmetric alopecia of the ventral abdomen and tail region, and vulvar enlargement with serous to mucopurulent discharge.38 Pale mucous membranes, petechiae and ecchymoses, hemorrhage, melena, coagulopathy, pneumonia, and pyometra are consequences of aplastic anemia, thrombocytopenia, and leukopenia in ferrets with bone marrow depression.11,56,108 Hemorrhage is the most common cause of death and the affected ferrets are typically in estrus for more than 2 months.108
The bone marrow depression is diagnosed by bone marrow cytology accompanied by history and clinical signs of prolonged estrus (such as enlarged and edematous vulva). Vaginal cytology from affected ferrets reveals cellular debris, abundant neutrophils and bacteria, and few erythrocytes.122
The major hematological changes reported in ferrets with prolonged estrus are thrombocytosis and neutrophilia followed by thrombocytopenia, neutropenia, lymphopenia, and anemia.56,108 The thrombocytopenia ranges between 20 000-50 000/μL with a platelet count less than 20 000/μL resulting in hemorrhage. Anemia progresses from normocytic normochromic to macrocytic hypochromic anemia. Reticulocyte and nucleated red blood cell counts increase with bone marrow regeneration. Clinical signs of bone marrow depression are apparent with PCV less than 20% and platelets below 50 000/μL. The serum protein concentration increases with low PCV and low hematocrit values. Erythroid hypoplasia causes mild anemia. Severe anemia is due to the combined effect of erythroid hypoplasia and hemorrhage due to thrombocytopenia.56
Bone marrow cytology from severely affected ferrets reveals hypocellularity with decreased erythroid, megakaryocytic and granulocytic precursors. The bone marrow contains 10-20% cellularity of hematopoietic cells, as well as the presence of adipocytes, lymphocytes, hemosiderin-laden macrophages, and erythrocytes.56
Gross lesions consistent with aplastic anemia include pale mucous membranes and thin watery blood. Petechiae, ecchymoses, hemorrhages in various organs and tissues, and melena from gastrointestinal hemorrhage are lesions associated with coagulopathy. The bone marrow is pale tan to red. Subdural hematoma or hematomyelia at the level of thoracic, lumbar, and sacral spinal cords may be present in ferrets with neurologic signs.11,108 Hydrometra or pyometra and mucoid to mucopurulent vaginitis due to bacterial infection are commonly reported in affected ferrets.72,108
Histologically, bone marrow depletion is characterized by absence of erythroid and granulocytic precursors and megakaryocytes. The hematopoietic tissue is replaced by abundant adipocytes and variable numbers of lymphocytes, plasma cells, and hemosiderophages. In affected ferrets, suppurative bronchopneumonia due to concurrent bacterial infections, cystic endometrial hyperplasia, hydrometra, mucometra, and pyometra are also frequently reported.11,56 Spleen, lymph nodes, liver, and lungs contain variable amounts of hemosiderosis, suggestive of hemorrhage.56
Mammary Gland Neoplasms
Mammary neoplasms are relatively uncommon in domestic ferrets.41 Both benign and malignant mammary neoplasms such as simple adenoma, complex adenoma and adenocarcinoma have been reported.63,76 The incidence of mammary neoplasia is relatively high (7%) in captive black-footed ferrets (Mustela nigripes).58
Testis
The testis and epididymis are located in the scrotum that lies beneath the base of the penis. In sexually mature ferrets, the testis measures 12-20 mm in length80 and weighs 0.18 to 2.1 gm.1 Testicular tumors such as interstitial cell tumor, seminoma, Sertoli cell tumor, carcinoma of rete testis, and benign peripheral nerve sheath tumor have been reported in middle-aged to older ferrets.7,29,50,93,120 Testes with multiple tumors have also been reported.7,120 Consistent with other domestic species, cryptorchid testes are more prone for tumor development.120
Sertoli Cell Tumors
Sertoli cell tumors are occasionally reported in middle-aged male ferrets.7,41,120 These tumors are unilateral or bilateral and enlarge the affected testes. Sertoli cell tumors arise from the sustentacular cells of the seminiferous tubules. On gross examination, these tumors are firm, pale tan, and compress the adjacent normal testicular parenchyma. Microscopically, these neoplasms are composed of elongate polygonal cells arranged in sheets and irregular tubules supported by moderate fibrovascular stroma. Neoplastic cells palisade along the basement membrane and fibrous stroma (Fig. 15). The neoplastic cells have distinct cell borders and scant to moderate vacuolated granular eosinophilic cytoplasm (Fig. 16). Nuclei are round to oval with stippled chromatin and distinct small basophilic nucleoli. Adjacent testicular parenchyma has extensive areas of necrosis, hemorrhage, and atrophied seminiferous tubules. Metastasis of a Sertoli cell tumor to the liver has been reported in a ferret.120
Figure 15.

Sertoli cell tumor, testis, ferret. Tubular structures are composed of multiple layers of neoplastic cells. The neoplastic cells are arranged perpendicular to the basement membrane (inset). HE.
Figure 16.

Higher magnification of Fig. 15. Neoplastic cells palisade around blood vessels. The elongated polygonal neoplastic cells have abundant eosinophilic granular cytoplasm with intracytoplasmic vacuoles. HE.
Interstitial Cell Tumors
Interstitial cell or Leydig cell tumors have been reported in a 5-year old male ferret.7 Interstitial cells of the testis are located between the seminiferous tubules and are responsible for synthesis of androgens in male ferrets. On gross examination these neoplasms are firm, yellow to orange, and nodular to multinodular in appearance. Microscopically, the expansile, poorly demarcated, and invasive (Fig. 17) neoplasm is composed of polyhedral neoplastic cells. The neoplastic cells are arranged in solid sheets and separated by fine fibrovascular connective tissue. The well-differentiated neoplastic cells have indistinct cell borders and moderate amounts of pale eosinophilic foamy vacuolated cytoplasm. Nuclei are large, oval to round, with finely stippled chromatin and 1-2 prominent nucleoli (Fig. 18). Mitotic figures are rare.
Figure 17.

Interstitial cell tumor, testicle, ferret. An expansile poorly demarcated neoplasm compresses the adjacent seminiferous tubules (on the left). HE.
Figure 18.

Higher magnification of Fig. 17. Sheets of well-differentiated large polygonal neoplastic cells contain abundant finely granular to vacuolated cytoplasm and large round nuclei. HE.
Thyroid Gland
The thyroid gland of the ferret is brown, 1.3 cm × 0.3 cm × 0.1 cm, and weighs 0.6 g. The thyroid gland is situated between the 3rd and 11th tracheal rings. The 2 lobes of the thyroid gland are connected by an isthmus. The arterial blood is supplied by cranial and caudal thyroid arteries from the carotid artery. The venous blood is drained into the jugular vein by cranial and caudal thyroid veins. The thyroid gland is innervated by the thyroid nerve from the cranial laryngeal nerve and cranial cervical ganglion.33
The normal triiodothyronine (T3) value ranges from 0.45 to 0.78 ng/mL for males and 0.29 to 0.73 ng/mL for females. The serum thyroxine (T4) values ranges from 1.01 to 8.29 μg/dL for males and 0.71 to 3.43 μg/dL for females.42 While T3 values are similar in both the sexes, T4 values for intact adult males are higher compared to females, castrated males, and juveniles.42 Thyroid function tests reveal an increase in T4 levels from 1.66 (prestimulation) to 2.32 (poststimulation) μg/dL after administration of thyroid-stimulating hormone in both male and female ferrets.74
Disease conditions affecting the thyroid glands are rarely reported in ferrets. A rare form of lymphoplasmacytic thyroiditis (Fig. 19) had been reported in ferrets that were positive for Aleutian disease parvovirus (ADV).35,75 Hyperthyroidism has not been reported in ferrets.75 Although congestive cardiomyopathies have been reported in ferrets,32,45,65 thyroid-associated cardiomyopathy has not been reported.
Figure 19.

Lymphoplasmacytic thyroiditis, ferret. Severe disruption of thyroid architecture by perifollicular aggregates of lymphocytes and plasma cells. Follicles within the affected area are collapsed and contain minimal amounts of colloid admixed with cellular debris. HE.
Hypothyroidism
Recently hypothyroidism was diagnosed and reported in ferrets. Clinical signs included lethargy, obesity, decreased activity, excessive sleeping, and rear leg weakness. The pathogenesis of hypothyroidism in ferrets remains to be elucidated.125
Thyroid Gland Neoplasms
Neoplasms such as adenomas and adenocarcinomas are rarely reported in ferrets.41,63,123 One report described a case of thyroid follicular adenocarcinoma in a 5-year-old castrated male ferret.123 Although thyroid hormone profiles were not evaluated in ferrets with thyroid tumors, the lack of any clinical manifestation suggested a nonfunctional thyroid tumor.41 On gross examination, the adenomas measured 2-3 mm in diameter. The adenocarcinomas were firm, sessile, and measured approximately 2 cm in size.41 Histologically, both adenomas and adenocarcinomas retained the characteristic follicular structures that contained colloid. The neoplastic cells were cuboidal to columnar, and arranged in cords with abundant eosinophilic cytoplasm (Fig. 20). Malignant features such as karyomegaly and high mitosis were present in thyroid follicular adenocarcinoma. Thyroid adenocarcinomas were immunoreactive to thyroid markers such as thyroglobulin (Fig. 21) and calcitonin.41
Figure 20.

Thyroid gland adenocarcinoma, ferret. Adapted from Wills et al.123 The neoplasm forms irregular follicles infiltrating adjacent muscle. Inset: The neoplastic follicular structures contain minimal amounts of colloid. HE.
Figure 21.

Thyroid gland adenocarcinoma, ferret. Adapted from Wills et al.123 Neoplastic cells lining follicles demonstrate cytoplasmic thyroglobulin expression. Immunohistochemistry for thyroglobulin.
A solitary case of C-cell carcinoma or thyroid medullary carcinoma was reported in a 4-year-old, castrated male ferret.39 On gross examination, the right thyroid gland had a 2-3 cm, dark red, poorly circumscribed mass (Fig. 22). Histologically, the neoplasm was composed of poorly differentiated polyhedral to spindle neoplastic cells arranged in irregular cords, lobules, and nests supported by dense fibrovascular connective tissue with areas of necrosis (Fig. 23). The cells had indistinct cell borders and scant to moderate eosinophilic vacuolated cytoplasm. The nuclei were round to oval with pale vesicular chromatin and indistinct nucleoli (Fig. 24). The neoplastic cells often palisaded around the blood vessels and mitotic figures were rare. Modified Grimelius stain revealed intracytoplasmic argyrophilic granules in the neoplastic cells consistent with that of a neuroendocrine origin of the neoplasm. Gross and histopathologic examination of other endocrine organs revealed adrenocortical adenoma, pheochromocytoma, and pancreatic islet cell tumor.39
Figure 22.

C-cell carcinoma, thyroid gland, ferret. An irregularly protruding mass on the ventrolateral aspect of the neck.
Figure 23.

C-cell carcinoma, thyroid gland, ferret. The neoplasm is composed of polygonal cells arranged in nests, packets, and anastomosing cords. Neoplastic cells are separated by dense fibrovascular connective tissue and often form necrotic foci. HE.
Figure 24.

Neoplastic cells have indistinct cell borders with scant vacuolated cytoplasm and oval to round nuclei. Neoplastic cells palisade around blood vessels. HE.
Parathyroid Gland
The parathyroid is a paired gland located on the craniomedial end of the thyroid gland between the fourth and fifth tracheal ring.33
Suspected cases of primary hypoparathyroidism27 and pseudohypoparathyroidism124 have been reported in a 4-year-old and 1.5-year-old castrated male ferret, respectively. Clinical signs and serum biochemical profile in both the ferrets included intermittent seizures, depression, hypocalcemia, and hyperphosphatemia without azotemia. The serum parathyroid hormone level was decreased in the ferret with suspected primary hypoparathyroidism and increased in the ferret with suspected pseudohypoparathyroidism. Both ferrets were successfully treated for hypocalcemia.27,124 Necropsy on the ferret with suspected primary hypoparathyroidism revealed hypertrophic cardiomyopathy and interstitial nephritis with unilateral chronic renal infarct. Unfortunately, the parathyroid glands were not examined.27
Pituitary Gland
Disease conditions affecting the pituitary gland are rarely reported in ferrets. Unlike other domestic animals, HAC in ferrets is not associated with pituitary lesions. The transient increase in number of gonadotrophs followed by loss of gonadotrophs in the pars-distalis suggests compensation and failure of the negative feedback mechanism working in tandem during the progression of adrenal disease.106
Pituitary gland neoplasms have been rarely reported in ferrets. Pituitary adenomas were reported in two 5-year-old, castrated male ferrets. Histologically, the adenomas were unencapsulated and composed of poorly differentiated, round, chromophobic, PAS-negative cells. The neoplastic cells had low cytoplasm to nuclear ratio and mitotic figures were rare. Similar to human gonadotroph adenomas, the neoplastic cells of ferret pituitary adenomas are characterized by lack of immunoreactivity for various pituitary hormones such as ACTH, α-MSH, GH, TSH, PRL, LH, and FSH.106
Conclusions
Proliferative and degenerative conditions affecting endocrine organs are the most common endocrinopathies encountered in ferrets and often affect middle-aged ferrets of either sex. Among the endocrine related diseases, the most notable are insulinomas and AAE; these are spontaneous, and a causative factor has not been identified. However, genetics, diet, and gonadectomy are presumed to play major roles as predisposing factors in their pathogenesis. To date, a common mechanism for the development of multiple endocrine neoplasms in ferrets has not been identified. Unlike human cases of MEN, mutations have not been identified in MEN genes of ferrets affected with multiple endocrine tumors. However, evaluation of epigenetic changes, post-transcriptional, and post-translational alterations in these genes and gene products may provide valuable insights into mechanisms operable in age-related endocrinopathies in ferrets. The role of aging in the development of endocrinopathy and/or spontaneous neoplasia in various endocrine systems of ferrets is relatively unexplored. The completion of the ferret genome sequencing project and ability to generate transgenic ferrets should help in unraveling the role of aging in development of these endocrine diseases.
Supplementary Material
Acknowledgments
We would like to thank Elaine C. Robbins for her technical assistance with preparation of figures and Alyssa Terestre Pappa for her assistance in manuscript preparation.
Funding: This work was supported by NIH grants P30-ES002109 (JGF) and T32-OD010978-26 (JGF).
Footnotes
Supplemental material for this article is available on the Veterinary Pathology website at http://vet.sagepub.com/supplemental.
Declaration of Conflicting Interests: The author(s) declared no potential conflicts of interest with respect to the research, authorship, and/or publication of this article.
References
- 1.Allanson M. The reproductive processes of certain mammals. III—the reproductive cycle of the male ferret. Proc Biol Sci. 1932;110(767):295–312. [Google Scholar]
- 2.Andrews GA, Myers NC, Chard-Bergstrom C. Immunohistochemistry of pancreatic islet cell tumors in the ferret (Mustela putorius furo) Vet Pathol. 1997;34(5):387–393. doi: 10.1177/030098589703400502. [DOI] [PubMed] [Google Scholar]
- 3.Antinoff N, Hahn K. Ferret oncology: diseases, diagnostics, and therapeutics. Vet Clin North Am Exot Anim Pract. 2004;7(3):579–625. doi: 10.1016/j.cvex.2004.05.001. [DOI] [PubMed] [Google Scholar]
- 4.Antinoff N, Williams BH. Neoplasia. In: Quesenberry KE, Carpenter JW, editors. Ferrets, Rabbits, and Rodents. 3rd. Saint Louis, MO: W.B. Saunders; 2012. pp. 103–121. [Google Scholar]
- 5.Ball RS. Issues to consider for preparing ferrets as research subjects in the laboratory. ILAR J. 2006;47(4):348–357. doi: 10.1093/ilar.47.4.348. [DOI] [PMC free article] [PubMed] [Google Scholar]
- 6.Bartlett LW. Ferret soft tissue surgery. Semin Avian Exot Pet Med. 2002;11(4):221–230. [Google Scholar]
- 7.Batista-Arteaga M, Suárez-Bonnet A, Santana M, Niño T, Reyes R, Alamo D. Testicular neoplasms (interstitial and sertoli cell tumours) in a domestic ferret (Mustela putorius furo) Reprod Domest Anim. 2011;46(1):177–180. doi: 10.1111/j.1439-0531.2009.01567.x. [DOI] [PubMed] [Google Scholar]
- 8.Beach JE. The ferret for non-rodent toxicity studies—a pathologist's view. Arch Toxicol Suppl. 1982;5:279–282. doi: 10.1007/978-3-642-68511-8_48. [DOI] [PubMed] [Google Scholar]
- 9.Benoit-Biancamano MO, Morin M, Langlois I. Histopathologic lesions of diabetes mellitus in a domestic ferret. Can Vet J. 2005;46(10):895–897. [PMC free article] [PubMed] [Google Scholar]
- 10.Berglund LA, Sisk CL. Pituitary responsiveness to luteinizing hormone-releasing hormone in prepubertal and postpubertal male ferrets. Biol Reprod. 1990;43(2):335–339. doi: 10.1095/biolreprod43.2.335. [DOI] [PubMed] [Google Scholar]
- 11.Bernard SL, Leathers CW, Brobst DF, Gorham JR. Estrogen-induced bone marrow depression in ferrets. Am J Vet Res. 1983;44(4):657–661. [PubMed] [Google Scholar]
- 12.Bielinska M, Kiiveri S, Parviainen H, Mannisto S, Heikinheimo M, Wilson DB. Gonadectomy-induced adrenocortical neoplasia in the domestic ferret (Mustela putorius furo) and laboratory mouse. Vet Pathol. 2006;43(2):97–117. doi: 10.1354/vp.43-2-97. [DOI] [PubMed] [Google Scholar]
- 13.Bielinska M, Parviainen H, Kiiveri S, Heikinheimo M, Wilson DB. Review paper: origin and molecular pathology of adrenocortical neoplasms. Vet Pathol. 2009;46(2):194–210. doi: 10.1354/vp.46-2-194. [DOI] [PMC free article] [PubMed] [Google Scholar]
- 14.Boari A, Papa V, Di Silverio F, Aste G, Olivero D, Rocconi F. Type 1 diabetes mellitus and hyperadrenocorticism in a ferret. Vet Res Commun. 2010;34(1):107–110. doi: 10.1007/s11259-010-9369-2. [DOI] [PubMed] [Google Scholar]
- 15.Boosinger TR, Zerbe CA, Grabau JH, Pletcher JM. Multihormonal pancreatic endocrine tumor in a dog with duodenal ulcers and hypertrophic gastropathy. Vet Pathol. 1988;25(3):237–239. doi: 10.1177/030098588802500309. [DOI] [PubMed] [Google Scholar]
- 16.Byrom AE. Dispersal and survival of juvenile feral ferrets Mustela furo in New Zealand. J Appl Ecol. 2002;39(1):67–78. [Google Scholar]
- 17.Caplan ER, Peterson ME, Mullen HS, et al. Diagnosis and treatment of insulin-secreting pancreatic islet cell tumors in ferrets: 57 cases (1986-1994) J Am Vet Med Assoc. 1996;209(10):1741–1745. [PubMed] [Google Scholar]
- 18.Carpenter JW, Novilla MN. Diabetes mellitus in a black-footed ferret. J Am Vet Med Assoc. 1977;171(9):890–893. [PubMed] [Google Scholar]
- 19.Chen S. Pancreatic endocrinopathies in ferrets. Vet Clin North Am Exot Anim Pract. 2008;11(1):107–123. doi: 10.1016/j.cvex.2007.09.001. [DOI] [PubMed] [Google Scholar]
- 20.Chesterman FC, Pomerance A. Spontaneous neoplasms in ferrets and polecats. J Pathol Bacteriol. 1965;89(2):529–533. [PubMed] [Google Scholar]
- 21.Coleman GD, Chavez MA, Williams BH. Cystic prostatic disease associated with adrenocortical lesions in the ferret (Mustela putorius furo) Vet Pathol. 1998;35(6):547–549. doi: 10.1177/030098589803500612. [DOI] [PubMed] [Google Scholar]
- 22.Cotchin E. Smooth-muscle hyperplasia and neoplasia in the ovaries of domestic ferrets (Mustela putorius furo) J Pathol. 1980;130(3):169–171. doi: 10.1002/path.1711300305. [DOI] [PubMed] [Google Scholar]
- 23.Cruz Cardona JA, Wamsley HL, Farina LL, Kiupel M. Metastatic pancreatic polypeptide-secreting islet cell tumor in a dog. Vet Clin Pathol. 2010;39(3):371–376. doi: 10.1111/j.1939-165X.2010.00243.x. [DOI] [PubMed] [Google Scholar]
- 24.Cullen JM, Page R, Misdorp W. An overview of cancer pathogenesis, diagnosis, and management. In: Meuten DJ, editor. Tumors in Domestic Animals. 4th. Ames: Iowa State University Press; 2008. pp. 1–44. [Google Scholar]
- 25.De Cock HEV, Maclachlan NJ. Simultaneous occurrence of multiple neoplasms and hyperplasias in the adrenal and thyroid gland of the horse resembling multiple endocrine neoplasia syndrome: case report and retrospective identification of additional cases. Vet Pathol. 1999;36(6):633–636. doi: 10.1354/vp.36-6-633. [DOI] [PubMed] [Google Scholar]
- 26.de Jong MK, ten Asbroek EEM, Sleiderink AJ, Conley AJ, Mol JA, Schoemaker NJ. Gonadectomy-related adrenocortical tumors in ferrets demonstrate increased expression of androgen and estrogen synthesizing enzymes together with high inhibin expression. Domest Anim Endocrinol. 2014;48(0):42–47. doi: 10.1016/j.domaniend.2014.02.002. [DOI] [PubMed] [Google Scholar]
- 27.de Matos RE, Connolly MJ, Starkey SR, Morrisey JK. Suspected primary hypoparathyroidism in a domestic ferret (Mustela putorius furo) J Am Vet Med Assoc. 2014;245(4):419–424. doi: 10.2460/javma.245.4.419. [DOI] [PubMed] [Google Scholar]
- 28.Desmarchelier M, Lair S, Dunn M, Langlois I. Primary hyperaldosteronism in a domestic ferret with an adrenocortical adenoma. J Am Vet Med Assoc. 2008;233(8):1297–1301. doi: 10.2460/javma.233.8.1297. [DOI] [PubMed] [Google Scholar]
- 29.Dillberger JE, Altman NH. Neoplasia in ferrets: eleven cases with a review. J Comp Pathol. 1989;100(2):161–176. doi: 10.1016/0021-9975(89)90127-8. [DOI] [PubMed] [Google Scholar]
- 30.Eatwell K. Two unusual tumours in a ferret (Mustela putorius furo) J Small Anim Pract. 2004;45(9):454–459. doi: 10.1111/j.1748-5827.2004.tb00264.x. [DOI] [PubMed] [Google Scholar]
- 31.Ehrhart N, Withrow SJ, Ehrhart EJ, Wimsatt JH. Pancreatic beta cell tumor in ferrets: 20 cases (1986-1994) J Am Vet Med Assoc. 1996;209(10):1737–1740. [PubMed] [Google Scholar]
- 32.Ensley PK, Winkle TV. Treatment of congestive heart failure in a ferret (Mustela putorius furo) J Zoo Wildl Med. 1982;13(1):23–25. [Google Scholar]
- 33.Evans H, An NQ. Anatomy of the ferret. In: Fox JG, Marini RP, editors. Biology and Diseases of the Ferret. 3rd. New York, NY: John Wiley; 2014. pp. 23–67. [Google Scholar]
- 34.Fix AS, Harms CA. Immunocytochemistry of pancreatic endocrine tumors in three domestic ferrets (Mustela putorius furo) Vet Pathol. 1990;27(3):199–201. doi: 10.1177/030098589002700308. [DOI] [PubMed] [Google Scholar]
- 35.Fox JG. Normal clinical and biological parameters. In: Fox JG, Marini RP, editors. Biology and Diseases of the Ferret. 3rd. New York, NY: John Wiley; 2014. pp. 157–185. [Google Scholar]
- 36.Fox JG. Taxonomy, history, and use. In: Fox JG, Marini RP, editors. Biology and Diseases of the Ferret. 3rd. New York, NY: John Wiley; 2014. pp. 1–22. [Google Scholar]
- 37.Fox JG, Bell J, Broome R. Growth and reproduction. In: Fox JG, Marini RP, editors. Biology and Diseases of the Ferret. 3rd. New York, NY: John Wiley; 2014. pp. 187–209. [Google Scholar]
- 38.Fox JG, Bell JA. Diseases of the genitourinary system. In: Fox JG, Marini RP, editors. Biology and Diseases of the Ferret. 3rd. New York, NY: John Wiley; 2014. pp. 335–361. [Google Scholar]
- 39.Fox JG, Dangler CA, Snyder SB, Richard MJ, Thilsted JP. C-cell carcinoma (medullary thyroid carcinoma) associated with multiple endocrine neoplasms in a ferret (Mustela putorius) Vet Pathol. 2000;37(3):278–282. doi: 10.1354/vp.37-3-278. [DOI] [PubMed] [Google Scholar]
- 40.Fox JG, Goad ME, Garibaldi BA, Wiest LM., Jr Hyperadrenocorticism in a ferret. J Am Vet Med Assoc. 1987;191(3):343–344. [PubMed] [Google Scholar]
- 41.Fox JG, Muthupalani S, Kiupel M, Williams B. Neoplastic diseases. In: Fox JG, Marini RP, editors. Biology and Diseases of the Ferret. 3rd. New York, NY: John Wiley; 2014. pp. 587–626. [Google Scholar]
- 42.Garibaldi BA, Pecquet Goad ME, Fox JG, Murray R. Serum thyroxine and triiodothyronine radioimmunoassay values in the normal ferret. Lab Anim Sci. 1988;38(4):455–458. [PubMed] [Google Scholar]
- 43.Gliatto JM, Alroy J, Schelling SH, Engler SJ, Dayal Y. A light microscopical, ultrastructural and immunohistochemical study of spindle-cell adrenocortical tumours of ferrets. J Comp Pathol. 1995;113(2):175–183. doi: 10.1016/s0021-9975(05)80032-5. [DOI] [PubMed] [Google Scholar]
- 44.Gould WJ, Reimers TJ, Bell JA, et al. Evaluation of urinary cortisol: creatinine ratios for the diagnosis of hyperadrenocorticism associated with adrenal gland tumors in ferrets. J Am Vet Med Assoc. 1995;206(1):42–46. [PubMed] [Google Scholar]
- 45.Greenlee PG, Stephens E. Meningeal cryptococcosis and congestive cardiomyopathy in a ferret. J Am Vet Med Assoc. 1984;184(7):840–841. [PubMed] [Google Scholar]
- 46.Hernádi A, Kis A, Turcsán B, Topál J. Man's underground best friend: domestic ferrets, unlike the wild forms, show evidence of dog-like social-cognitive skills. PLOS ONE. 2012;7(8):e43267. doi: 10.1371/journal.pone.0043267. [DOI] [PMC free article] [PubMed] [Google Scholar]
- 47.Hess L. Insulin glargine treatment of a ferret with diabetes mellitus. J Am Vet Med Assoc. 2012;241(11):1490–1494. doi: 10.2460/javma.241.11.1490. [DOI] [PubMed] [Google Scholar]
- 48.Hoar RM. Use of ferrets in toxicity testing. Int J Toxicol. 1984;3(6):325–330. [Google Scholar]
- 49.Hoefer HL, Patnaik AK, Lewis AD. Pancreatic adenocarcinoma with metastasis in two ferrets. J Am Vet Med Assoc. 1992;201(3):466–467. [PubMed] [Google Scholar]
- 50.Hohšteter M, Smolec O, Gudan Kurilj A, Šoštarić'-Zuckerman IC, Bata I, Grabarevi Ž. Intratesticular benign peripheral nerve sheath tumour in a ferret (Mustela putorius furo) J Small Anim Pract. 2012;53(1):63–66. doi: 10.1111/j.1748-5827.2011.01145.x. [DOI] [PubMed] [Google Scholar]
- 51.Holmes RL. The adrenal glands of the ferret, Mustela putorius. J Anat. 1961;95:325–336. [PMC free article] [PubMed] [Google Scholar]
- 52.Hoppes SM. The senior ferret (Mustela putorius furo) Vet Clin North Am Exot Anim Pract. 2010;13(1):107–122. doi: 10.1016/j.cvex.2009.12.002. [DOI] [PMC free article] [PubMed] [Google Scholar]
- 53.Jekl V, Hauptman K, Jeklová E, Dorrestein GM, Knotek Z. Hydrometra in a ferret—case report. Vet Clin North Am Exot Anim Pract. 2006;9(3):695–700. doi: 10.1016/j.cvex.2006.05.029. [DOI] [PubMed] [Google Scholar]
- 54.Johnson-Delaney CA. Proceedings of the North American Veterinary Conference: Small Animal and Exotics. Gainesville, FL: North American Veterinary Conference; 2008. Update on the ferret genome project; p. 1815. [Google Scholar]
- 55.Kiupel M, Mueller PB, Ramos Vara J, Irizarry A, Lin TL. Multiple endocrine neoplasia in a dog. J Comp Pathol. 2000;123(2-3):210–217. doi: 10.1053/jcpa.2000.0407. [DOI] [PubMed] [Google Scholar]
- 56.Kociba GJ, Caputo CA. Aplastic anemia associated with estrus in pet ferrets. J Am Vet Med Assoc. 1981;178(12):1293–1294. [PubMed] [Google Scholar]
- 57.Kuijten AM, Schoemaker NJ, Voorhout G. Ultrasonographic visualization of the adrenal glands of healthy ferrets and ferrets with hyperadrenocorticism. J Am Anim Hosp Assoc. 2007;43(2):78–84. doi: 10.5326/0430078. [DOI] [PubMed] [Google Scholar]
- 58.Lair S, Barker IK, Mehren KG, Williams ES. Epidemiology of neoplasia in captive black-footed ferrets (Mustela nigripes), 1986-1996. J Zoo Wildl Med. 2002;33(3):204–213. doi: 10.1638/1042-7260(2002)033[0204:EONICB]2.0.CO;2. [DOI] [PubMed] [Google Scholar]
- 59.Lakhani VT, You YN, Wells SA. The multiple endocrine neoplasia syndromes. Annu Rev Med. 2007;58(1):253–265. doi: 10.1146/annurev.med.58.100305.115303. [DOI] [PubMed] [Google Scholar]
- 60.Lewington J. Endocrine diseases. In: Lewington JH, editor. Ferret Husbandry, Medicine and Surgery. 2nd. Edinburgh, UK: W.B. Saunders; 2007. pp. 346–379. [Google Scholar]
- 61.Li X, Fox JG. Neoplastic diseases. In: Fox JG, editor. Biology and Diseases of the Ferret. 2nd. New York, NY: John Wiley; 1998. pp. 405–447. [Google Scholar]
- 62.Li X, Fox JG, Erdman SE, Lipman NS, Murphy JC. Cystic urogenital anomalies in ferrets (Mustela putorius furo) Vet Pathol. 1996;33(2):150–158. doi: 10.1177/030098589603300204. [DOI] [PubMed] [Google Scholar]
- 63.Li X, Fox JG, Padrid PA. Neoplastic diseases in ferrets: 574 cases (1968-1997) J Am Vet Med Assoc. 1998;212(9):1402–1406. [PubMed] [Google Scholar]
- 64.Lipman NS, Marini RP, Murphy JC, Zhibo Z, Fox JG. Estradiol-17 beta-secreting adrenocortical tumor in a ferret. J Am Vet Med Assoc. 1993;203(11):1552–1555. [PubMed] [Google Scholar]
- 65.Lipman NS, Murphy JC, Fox JG. Clinical, functional and pathologic changes associated with a case of dilatative cardiomyopathy in a ferret. Lab Anim Sci. 1987;37(2):210–212. [PubMed] [Google Scholar]
- 66.Lloyd CG, Lewis WG. Two cases of pancreatic neoplasia in British ferrets (Mustela putorius furo) J Small Anim Pract. 2004;45(11):558–562. doi: 10.1111/j.1748-5827.2004.tb00204.x. [DOI] [PubMed] [Google Scholar]
- 67.Lumeij J, van der Hage M, Dorrestein G, van Sluijs F. Hypoglycaemia due to a functional pancreatic islet cell tumour (insulinoma) in a ferret (Mustela putorius furo) Vet Rec. 1987;120(6):129–130. doi: 10.1136/vr.120.6.129. [DOI] [PubMed] [Google Scholar]
- 68.Lurye JC, Behrend EN. Endocrine tumors. Vet Clin North Am Small Anim Pract. 2001;31(5):1083–1110. doi: 10.1016/s0195-5616(01)50014-5. [DOI] [PubMed] [Google Scholar]
- 69.Luttgen PJ, Storts RW, Rogers KS, Morton LD. Insulinoma in a ferret. J Am Vet Med Assoc. 1986;189(8):920–921. [PubMed] [Google Scholar]
- 70.Marini RP, Ryden EB, Rosenblad WD, Murphy JC, Fox JG. Functional islet cell tumor in six ferrets. J Am Vet Med Assoc. 1993;202(3):430–433. [PubMed] [Google Scholar]
- 71.Martell R, Cohen H. The science of neoplasia and its relationship to aging. In: Cassel CK, editor. Geriatric Medicine. New York, NY: Springer; 2003. pp. 363–373. [Google Scholar]
- 72.Martínez-Jiménez D, Chary P, Barron HW, Hernández-Divers SJ, Basseches J. Cystic endometrial hyperplasia-pyometra complex in two female ferrets (Mustela putorius furo) J Exot Pet Med. 2009;18(1):62–70. [Google Scholar]
- 73.Maxwell J, O'Dorisio TM, Bellizzi AM, Howe JR. Elevated pancreatic polypeptide levels in pancreatic neuroendocrine tumors and diabetes mellitus: causation or association? Pancreas. 2014;43(4):651–656. doi: 10.1097/MPA.0000000000000082. [DOI] [PMC free article] [PubMed] [Google Scholar]
- 74.Mayer J, Wagner R, Mitchell MA, Fecteau K. Use of recombinant human thyroid-stimulating hormone for thyrotropin stimulation testing in euthyroid ferrets. J Am Vet Med Assoc. 2013;243(10):1432–1435. doi: 10.2460/javma.243.10.1432. [DOI] [PubMed] [Google Scholar]
- 75.Miller CL, Marini RP, Fox JG. Diseases of the endocrine system. In: Fox JG, Marini RP, editors. Biology and Diseases of the Ferret. 3rd. New York, NY: John Wiley; 2014. pp. 377–399. [Google Scholar]
- 76.Miwa Y, Kurosawa A, Ogawa H, Nakayama H, Sasai H, Sasaki N. Neoplasitic diseases in ferrets in Japan: a questionnaire study for 2000 to 2005. J Vet Med Sci. 2009;71(4):397–402. doi: 10.1292/jvms.71.397. [DOI] [PubMed] [Google Scholar]
- 77.Miwa Y, Nakata M, Kurosawa A, Sasai H, Sasaki N. Adrenal diseases in ferrets in Japan. J Vet Med Sci. 2008;70(12):1323–1326. doi: 10.1292/jvms.70.1323. [DOI] [PubMed] [Google Scholar]
- 78.Miwa Y, Uchida K, Nakayama H, Asaki N. Neuroblastoma of the adrenal gland in a ferret. J Vet Med Sci. 2010;72(9):1229–1232. doi: 10.1292/jvms.09-0548. [DOI] [PubMed] [Google Scholar]
- 79.Narama I, Nakahara Y, Ano N, Nomura K, Ozaki K. European Society of Veterinary Pathology. Edinburgh, UK: European Society of Veterinary Pathology; 2006. Adrenal epithelial-lined cysts in the ferrets; pp. 209–210. [Google Scholar]
- 80.Neal J, Murphy BD, Moger WH, Oliphant LW. Reproduction in the male ferret: gonadal activity during the annual cycle; recrudescence and maturation. Biol Reprod. 1977;17(3):380–385. doi: 10.1095/biolreprod17.3.380. [DOI] [PubMed] [Google Scholar]
- 81.Newman SJ, Bergman PJ, Williams B, Scase T, Craft D. Characterization of spindle cell component of ferret (Mustela putorius furo) adrenal cortical neoplasms—correlation to clinical parameters and prognosis. Vet Comp Oncol. 2004;2(3):113–124. doi: 10.1111/j.1476-5810.2004.00044.x. [DOI] [PubMed] [Google Scholar]
- 82.O'Brien TD, Hayden DW, O'Leary TP, Caywood DD, Johnson KH. Canine pancreatic endocrine tumors: immunohistochemical analysis of hormone content and amyloid. Vet Pathol. 1987;24(4):308–314. doi: 10.1177/030098588702400404. [DOI] [PubMed] [Google Scholar]
- 83.Paradis M, Bonneau NH, Morin M, Scott DW. Hyperadrenocorticism in association with an adrenocortical adenoma in a pet ferret. Can Vet J. 1989;30(1):60–62. [PMC free article] [PubMed] [Google Scholar]
- 84.Patterson MM, Rogers AB, Schrenzel MD, Marini RP, Fox JG. Alopecia attributed to neoplastic ovarian tissue in two ferrets. Comp Med. 2003;53(2):213–217. [PubMed] [Google Scholar]
- 85.Paulsson JF, Benoit-Biancamano MO, Schäffer L, Dahl K. Ferret islet amyloid polypeptide (IAPP): characterization of in vitro and in vivo amyloidogenicity. Amyloid. 2011;18(4):222–228. doi: 10.3109/13506129.2011.627956. [DOI] [PubMed] [Google Scholar]
- 86.Peng X, Alfoldi J, Gori K, et al. The draft genome sequence of the ferret (Mustela putorius furo) facilitates study of human respiratory disease. Nat Biotech. 2014;32(12):1250–1255. doi: 10.1038/nbt.3079. [DOI] [PMC free article] [PubMed] [Google Scholar]
- 87.Peterson RA, Kiupel M, Bielinska M, et al. Transcription factor GATA-4 is a marker of anaplasia in adrenocortical neoplasms of the domestic ferret (Mustela putorius furo) Vet Pathol. 2004;41(4):446–449. doi: 10.1354/vp.41-4-446. [DOI] [PubMed] [Google Scholar]
- 88.Peterson RA, Kiupel M, Capen CC. Adrenal cortical carcinomas with myxoid differentiation in the domestic ferret (Mustela putorius furo) Vet Pathol. 2003;40(2):136–142. doi: 10.1354/vp.40-2-136. [DOI] [PubMed] [Google Scholar]
- 89.Phair KA, Carpenter JW, Schermerhorn T, Ganta CK, DeBey BM. Diabetic ketoacidosis with concurrent pancreatitis, pancreatic β islet cell tumor, and adrenal disease in an obese ferret (Mustela putorius furo) J Am Assoc Lab Anim Sci. 2011;50(4):531–535. [PMC free article] [PubMed] [Google Scholar]
- 90.Phay JE, Moley JF, Lairmore TC. Multiple endocrine neoplasias. Semin Surg Oncol. 2000;18(4):324–332. doi: 10.1002/(sici)1098-2388(200006)18:4<324::aid-ssu7>3.0.co;2-5. [DOI] [PubMed] [Google Scholar]
- 91.Piecha G, Chudek J, Wiecek A. Multiple endocrine neoplasia type 1. Eur J Intern Med. 2008;19(2):99–103. doi: 10.1016/j.ejim.2007.08.004. [DOI] [PubMed] [Google Scholar]
- 92.Pollock C. Mycobacterial infection in the ferret. Vet Clin North Am Exot Anim Pract. 2012;15(1):121–129. vii. doi: 10.1016/j.cvex.2011.09.002. [DOI] [PubMed] [Google Scholar]
- 93.Pollock CG. Disorders of the urinary and reproductive systems. In: Quesenberry KE, Carpenter JW, editors. Ferrets, Rabbits, and Rodents. 3rd. Saint Louis, MO: W.B. Saunders; 2012. pp. 46–61. [Google Scholar]
- 94.Protain HJ, Kutzler MA, Valentine BA. Assessment of cytologic evaluation of preputial epithelial cells as a diagnostic test for detection of adrenocortical disease in castrated ferrets. Am J Vet Res. 2009;70(5):619–623. doi: 10.2460/ajvr.70.5.619. [DOI] [PubMed] [Google Scholar]
- 95.Proverbio D, Spada E, Perego R, et al. Potential variant of multiple endocrine neoplasia in a dog. J Am Anim Hosp Assoc. 2012;48(2):132–138. doi: 10.5326/JAAHA-MS-5708. [DOI] [PubMed] [Google Scholar]
- 96.Roccabianca P, Rondena M, Paltrinieri S, et al. Multiple endocrine neoplasia type-i-like syndrome in two cats. Vet Pathol. 2006;43(3):345–352. doi: 10.1354/vp.43-3-345. [DOI] [PubMed] [Google Scholar]
- 97.Rosenthal KL. Adrenal gland disease in ferrets. Vet Clin North Am Small Anim Pract. 1997;27(2):401–418. doi: 10.1016/s0195-5616(97)50039-8. [DOI] [PubMed] [Google Scholar]
- 98.Rosenthal KL, Peterson ME. Evaluation of plasma androgen and estrogen concentrations in ferrets with hyperadrenocorticism. J Am Vet Med Assoc. 1996;209(6):1097–1102. [PubMed] [Google Scholar]
- 99.Rosenthal KL, Peterson ME. Stranguria in a castrated male ferret. J Am Vet Med Assoc. 1996;209(1):62–63. discussion 63-64. [PubMed] [Google Scholar]
- 100.Rosenthal KL, Peterson ME, Quesenberry KE, et al. Hyperadrenocorticism associated with adrenocortical tumor or nodular hyperplasia of the adrenal gland in ferrets: 50 cases (1987-1991) J Am Vet Med Assoc. 1993;203(2):271–275. [PubMed] [Google Scholar]
- 101.Rosenthal KL, Wyre NR. Endocrine diseases. In: Quesenberry KE, Carpenter JW, editors. Ferrets, Rabbits, and Rodents. 3rd. Saint Louis, MO: W.B. Saunders; 2012. pp. 86–102. [Google Scholar]
- 102.Schillebeeckx M, Pihlajoki M, Gretzinger E, et al. Novel markers of gonadectomy-induced adrenocortical neoplasia in the mouse and ferret. Mol Cell Endocrinol. 2015;399(0):122–130. doi: 10.1016/j.mce.2014.09.029. [DOI] [PMC free article] [PubMed] [Google Scholar]
- 103.Schoemaker NJ, Kuijten AM, Galac S. Luteinizing hormone-dependent Cushing's syndrome in a pet ferret (Mustela putorius furo) Domest Anim Endocrinol. 2008;34(3):278–283. doi: 10.1016/j.domaniend.2007.08.001. [DOI] [PubMed] [Google Scholar]
- 104.Schoemaker NJ, Mol JA, Lumeij JT, Rijnberk A. I plasma concentrations of adrenocorticotrophic hormone and alpha-melanocyte-stimulating hormone in ferrets (Mustela putorius furo) with hyperadrenocorticism. Am J Vet Res. 2002;63(10):1395–1399. doi: 10.2460/ajvr.2002.63.1395. [DOI] [PubMed] [Google Scholar]
- 105.Schoemaker NJ, Teerds KJ, Mol JA, Lumeij JT, Thijssen JH, Rijnberk A. The role of luteinizing hormone in the pathogenesis of hyperadrenocorticism in neutered ferrets. Mol Cell Endocrinol. 2002;197(1-2):117–125. doi: 10.1016/s0303-7207(02)00285-x. [DOI] [PubMed] [Google Scholar]
- 106.Schoemaker NJ, van der Hage MH, Flik G, Lumeij JT, Rijnberk A. Morphology of the pituitary gland in ferrets (Mustela putorius furo) with hyperadrenocorticism. J Comp Pathol. 2004;130(4):255–265. doi: 10.1016/j.jcpa.2003.11.004. [DOI] [PubMed] [Google Scholar]
- 107.Schoemaker NJ, van Zeeland Y. Endocrine diseases in ferrets. EJCAP. 2013;23(4):19–30. [Google Scholar]
- 108.Sherrill A, Gorham J. Bone marrow hypoplasia associated with estrus in ferrets. Lab Anim Sci. 1985;35(3):280–286. [PubMed] [Google Scholar]
- 109.Shoemaker NJ, Schuurmans M, Moorman H, Lumeij JT. Correlation between age at neutering and age at onset of hyperadrenocorticism in ferrets. J Am Vet Med Assoc. 2000;216(2):195–197. doi: 10.2460/javma.2000.216.195. [DOI] [PubMed] [Google Scholar]
- 110.Simone-Freilicher E. Adrenal gland disease in ferrets. Vet Clin North Am Exot Anim Pract. 2008;11(1):125–137. vii. doi: 10.1016/j.cvex.2007.09.004. [DOI] [PubMed] [Google Scholar]
- 111.Smith M, Schulman FY. Subcutaneous Neoplasms of the Ventral Abdomen with Features of Adrenocortical Tumors in Two Ferrets. Vet Pathol. 2007;44(6):951–955. doi: 10.1354/vp.44-6-951. [DOI] [PubMed] [Google Scholar]
- 112.Sponenberg DP, McEntee K. Pheochromocytomas and ultimobranchial (c-cell) neoplasms in the bull: evidence of autosomal dominant inheritance in the guernsey breed. Vet Pathol. 1983;20(4):396–400. doi: 10.1177/030098588302000402. [DOI] [PubMed] [Google Scholar]
- 113.Swiderski JK, Seim HB, III, MacPhail CM, Campbell TW, Johnston MS, Monnet E. Long-term outcome of domestic ferrets treated surgically for hyperadrenocorticism: 130 cases (1995-2004) J Am Vet Med Assoc. 2008;232(9):1338–1343. doi: 10.2460/javma.232.9.1338. [DOI] [PubMed] [Google Scholar]
- 114.Thakker RV, Newey PJ, Walls GV, et al. Clinical practice guidelines for multiple endocrine neoplasia type 1 (MEN1) J Clin Endocrinol Metab. 2012;97(9):2990–3011. doi: 10.1210/jc.2012-1230. [DOI] [PubMed] [Google Scholar]
- 115.Wagner S, Kiupel M, Peterson RA, Heikinheimo M, Wilson DB. Cytochrome b5 expression in gonadectomy-induced adrenocortical neoplasms of the domestic ferret (Mustela putorius furo) Vet Pathol. 2008;45(4):439–442. doi: 10.1354/vp.45-4-439. [DOI] [PMC free article] [PubMed] [Google Scholar]
- 116.Walker MC, Jones BR, Guildford WG, Burbidge HM, Alley MR. Multiple endocrine neoplasia type 1 in a crossbred dog. J Small Anim Pract. 2000;41(2):67–70. doi: 10.1111/j.1748-5827.2000.tb03165.x. [DOI] [PubMed] [Google Scholar]
- 117.Weiss CA, Scott MV. Clinical aspects and surgical treatment of hyperadrenocorticism in the domestic ferret: 94 cases (1994-1996) J Am Anim Hosp Assoc. 1997;33(6):487–493. doi: 10.5326/15473317-33-6-487. [DOI] [PubMed] [Google Scholar]
- 118.Weiss CA, Williams BH, Scott MV. Insulinoma in the ferret: clinical findings and treatment comparison of 66 cases. J Am Anim Hosp Assoc. 1998;34(6):471–475. doi: 10.5326/15473317-34-6-471. [DOI] [PubMed] [Google Scholar]
- 119.Wheler CL, Kamieniecki CL. Ferret adrenal-associated endocrinopathy. Can Vet J. 1998;39(3):175–176. [PMC free article] [PubMed] [Google Scholar]
- 120.Williams BH, Weiss CA. Neoplasia. In: Quesenberry KE, Carpenter JW, editors. Ferrets, Rabbits, and Rodents. 2nd. Saint Louis, MO: W.B. Saunders; 2004. pp. 91–106. [Google Scholar]
- 121.Williams BH, Yantis LD, Craig SL, Geske RS, Li X, Nye R. Adrenal teratoma in four domestic ferrets (Mustela putorius furo) Vet Pathol. 2001;38(3):328–331. doi: 10.1354/vp.38-3-328. [DOI] [PubMed] [Google Scholar]
- 122.Williams ES, Thorne ET, Kwiatkowski DR, Lutz K, Anderson SL. Comparative vaginal cytology of the estrous cycle of black-footed ferrets (Mustela nigripes), Siberian polecats (M. eversmanni), and domestic ferrets (M. putorius furo) J Vet Diagn Invest. 1992;4(1):38–44. doi: 10.1177/104063879200400109. [DOI] [PubMed] [Google Scholar]
- 123.Wills TB, Bohn AA, Finch NP, Harris SP, Caplazi P. Thyroid follicular adenocarcinoma in a ferret. Vet Clin Pathol. 2005;34(4):405–408. doi: 10.1111/j.1939-165x.2005.tb00070.x. [DOI] [PubMed] [Google Scholar]
- 124.Wilson GH, Greene CE, Greenacre CB. Suspected pseudohypoparathyroidism in a domestic ferret. J Am Vet Med Assoc. 2003;222(8):1093–1096. doi: 10.2460/javma.2003.222.1093. [DOI] [PubMed] [Google Scholar]
- 125.Wyre NR, Michels D, Chen S. Selected emerging diseases in ferrets. Vet Clin North Am Exot Anim Pract. 2013;16(2):469–493. doi: 10.1016/j.cvex.2013.02.003. [DOI] [PMC free article] [PubMed] [Google Scholar]
Associated Data
This section collects any data citations, data availability statements, or supplementary materials included in this article.
